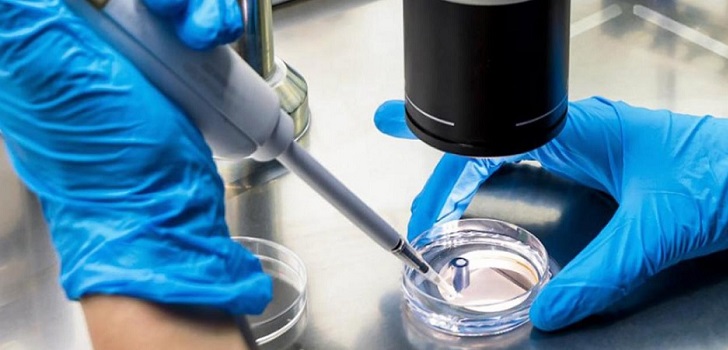
Imagen de una persona en un laboratorio La ‘biotech’ de grupo Pikolin aspira a llevar sus ensayos clínicos a seis hospitales en 2019

La ‘biotech’ de grupo Pikolin aspira a llevar sus ensayos clínicos a seis hospitales en 2019
La compañía biotecnológica española aspira a incrementar la presencia que tiene en los hospitales Dexeus, la Teknon, el Hospital Universitari Sagrat Cor y el Hospital General de Catalunya.
5 dic 2018 - 05:00
Pangaea Oncology avanza en el mercado biotecnológico español. La compañía, que está controlada al 40% por la familia Solans, propietaria del grupo Pikolin, aspira a aumentar su presencia en centros hospitalarios el año que viene.
En la actualidad, la biotech española centra su actividad en cuatro hospitales catalanes, en Sant Cugat del Vallès, así como en Barcelona: el Hospital Universiatri Dexeus, el Centro Médico Teknon, el Hospital Universitari Sagrat Cor y el Hospital Universitari General de Catalunya. El objetivo inicial marcado por la firma es estar presente en dos centros hospitalarios más el año que viene, en plazas que no necesariamente tendrían que ser la capital catalana, comenta Javier Rivela, consejero delegado de la cotizada.
Este plan de expansión vendría acompañado de la apertura de nuevas oficinas en España. En declaraciones de Rivela a PlantaDoce, “nuestra carta a los reyes magos contempla la posibilidad de abrir nuevas consultas en una de las grandes ciudades de la geografía española el año que viene”.
Pangaea Oncology prevé entrar en nuevas áreas terapéuticas como anatomía patológica y neumología
La compañía de servicios médicos centrada en oncología de precisión continuará con su apuesta por este sector de actividad, aunque en los planes de Pangea Oncology también está la incursión en áreas terapéuticas como anatomía patológica y neumología.
Entre los últimos contratos llevados a cabo por Pangaea Oncology destaca la novación del acuerdo de licencia y distribución con Labco (ahora Synlab) en biopsia líquida hasta el final de 2023. Con el nuevo acuerdo se incrementa el periodo de vigencia de este a cuatro años adicionales, desde el 1 de diciembre de 2019 que finalizaba el anterior al nuevo que vence el 31 de diciembre de 2023.
Por otra parte, en la primera mitad del año, la compañía biotecnológica selló un acuerdo de colaboración con la multinacional de diagnóstico alemana Qiagen. El convenio cuenta con una duración inicial de tres años, prorrogables anualmente por mutuo acuerdo, y gracias al mismo se desarrollará de manera conjunta una tecnología de diagnóstico molecular en biopsia líquida multiplexada (para varios genes). En virtud del acuerdo, las compañías van a cooperar en la cartera de clientes farmacéuticos para potenciar la venta cruzada de capacidades de ambas compañías.
La compañía incrementó sus ventas un 33,2% en el primer semestre del año, hasta 1,6 millones
Según los últimos resultados, la compañía incrementó sus ventas un 33,2% en el primer semestre del año, hasta 1,6 millones de euros, gracias a un aumento en su número de pacientes y clientes de la industria farmacéutica. Por divisiones, los ingresos por gestión asistencial aumentaron un 44,1%, mientras que los del área de diagnóstico molecular crecieron un 20,8%.
A cierre de año, la compañía mantiene una adecuada estructura de la deuda bruta como compañía en crecimiento, con un 59% de la deuda con vencimiento entre el segundo del ejercicio 2020 y 2030.
La empresa está controlada al 40% por la familia Solans, de grupo Pikolin; al 36% por el equipo gestor, liderado por Javier Rivela; al 14% por la familia Domínguez de Gor, propietaria de Mayoral, mientras que el resto es capital flotante.